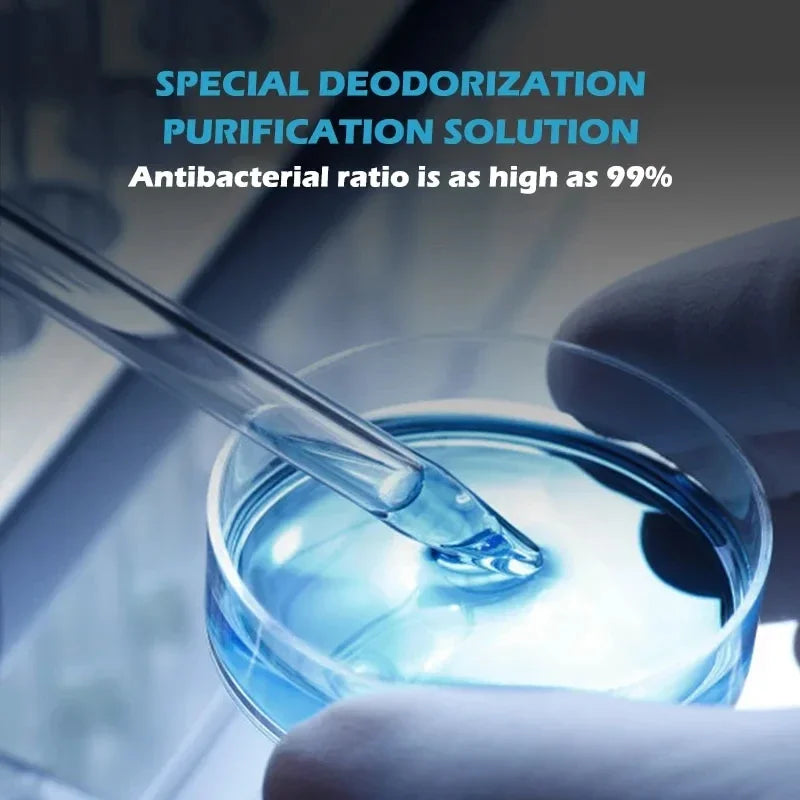
PETKIT PURA MAX Cat Litter Box Accessoriess Original Smart K3 Spray Odor Eliminator N50 Cat Toilet Odor Control Air Cleaning

1
/
of
12
AIAZ
PETKIT PURA MAX Cat Litter Box Accessoriess Original Smart K3 Spray Odor Eliminator N50 Cat Toilet Odor Control Air Cleaning
PETKIT PURA MAX Cat Litter Box Accessoriess Original Smart K3 Spray Odor Eliminator N50 Cat Toilet Odor Control Air Cleaning
Regular price
Dhs. 133.68 AED
Regular price
Dhs. 0.00 AED
Sale price
Dhs. 133.68 AED
Unit price
/
per
Taxes included.
Shipping calculated at checkout.
Couldn't load pickup availability
SPECIFICATIONS
Brand Name: NoEnName_Null
Choice: yes
Hign-concerned Chemical: None
Item Type: Cat Cleaning Tools
Origin: Mainland China
Set Type: Yes
semi_Choice: yes
Share